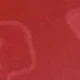
Nhiều màu (3 hình ảnh)

Bộ 3 lá bài trò chơi hội thoại tiếng Anh dành cho các cặp đôi, quà tặng ngày Valentine, tạo nên buổi hẹn hò hoàn hảo, tăng cường sự thấu hiểu lẫn nhau, trò chơi vui nhộn, đêm chơi game đầy niềm vui (1 hộp gồm 20/55 lá bài ngẫu nhiên)
SKU: sh260106170683109489875
Price and availability
40.500₫
Màu sắc:Nhiều màu
Ảnh lớn

Xin lỗi, sản phẩm này đã được bán hết.
Tìm hiểu thêm
An ninh mua sắm
Thanh toán an toàn
Bảo vệ quyền riêng tư